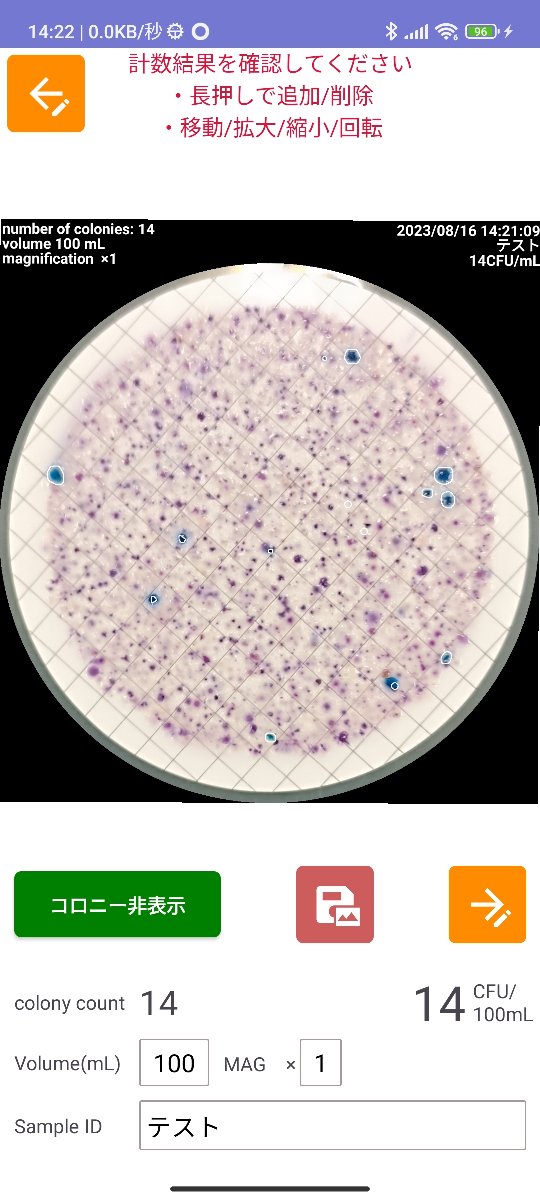
試料名入力
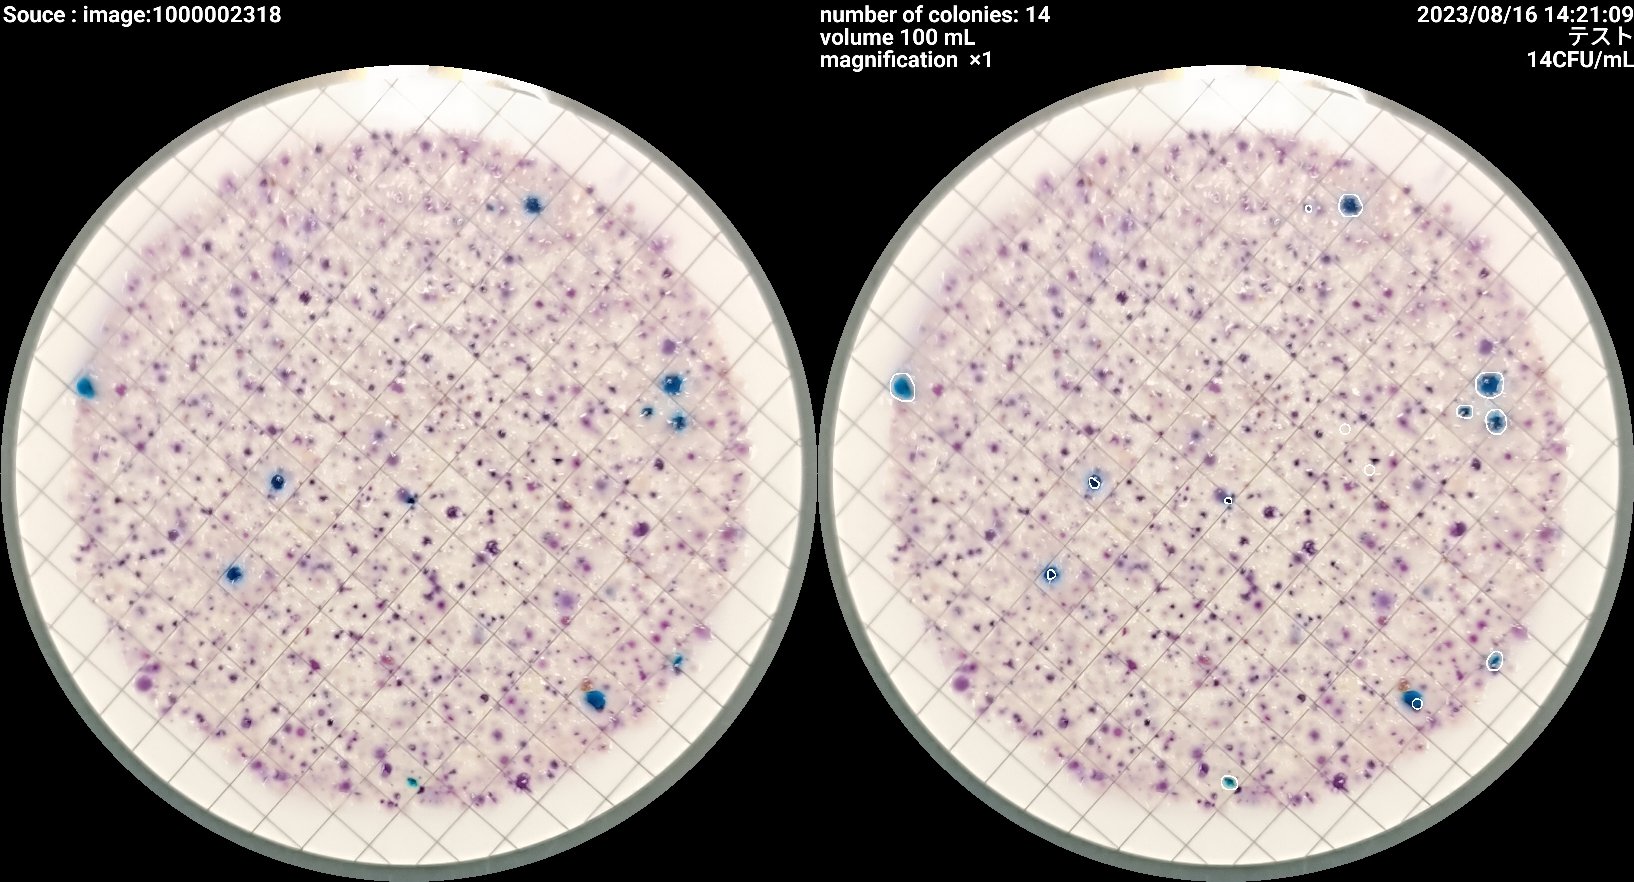
保存イメージ

大腸菌数コロニーカウンター
大腸菌数コロニーカウンター
大腸菌計数補助アプリ
アプリについて
令和4年より水質基準の「大腸菌数」表記が変更され、令和7年からは排水基準も対象となります。本アプリは、青色コロニーをスマホカメラや画像から自動で検出・計測し、EPA・ISO・日本基準に対応した方法で記録・出力が可能です。
計量証明事業所や試験機関での実務を想定し、操作性と正確性を重視しています。
アプリの主な流れ
ダウンロード
Google Play で入手できます。

今すぐダウンロード
画像選択
カメラまたは撮影済み画像を選択して分析を開始します。

起動画面でソースを選択

測定範囲を指定して青色ボタンを押す
自動検出
青色に近い領域のコロニーを自動で検出し、白枠で囲って表示します。

検出されたコロニーが白枠で表示され、計測値が表示されます。
確認修正
検出結果を拡大表示で確認・修正。追加や削除も可能です。

誤検出部分を確認

長押しで削除

長押しで追加
試料名等入力
試料名・希釈倍率・試料量を入力します。
入力後、自動で最終数値に反映されます。
データ保存
データは自動保存、画像は任意で保存可能です。

戻る・次の測定時に自動保存。赤ボタンで画像保存。
元画像と加工画像を同時保存。
CSV出力
履歴ページからCSV形式で結果を保存できます。

右上の履歴ボタンからアクセス

CSV形式で保存フォルダを選択可能
保存先について
初期保存先はスマートフォンの「Documents」フォルダです。
更新履歴
- 2024/07/15 ver2.1.1
カメラ処理とUI改善、API対応、計測精度改善、広告形式の見直しなど。 - 2023/09/18 ver1.5
データ保存先変更対応、バグ修正。 - 2023/09/02 ver1.2
CSV文字化け修正、削除・編集機能追加。 - 2023/08/17 ver1.0 公開